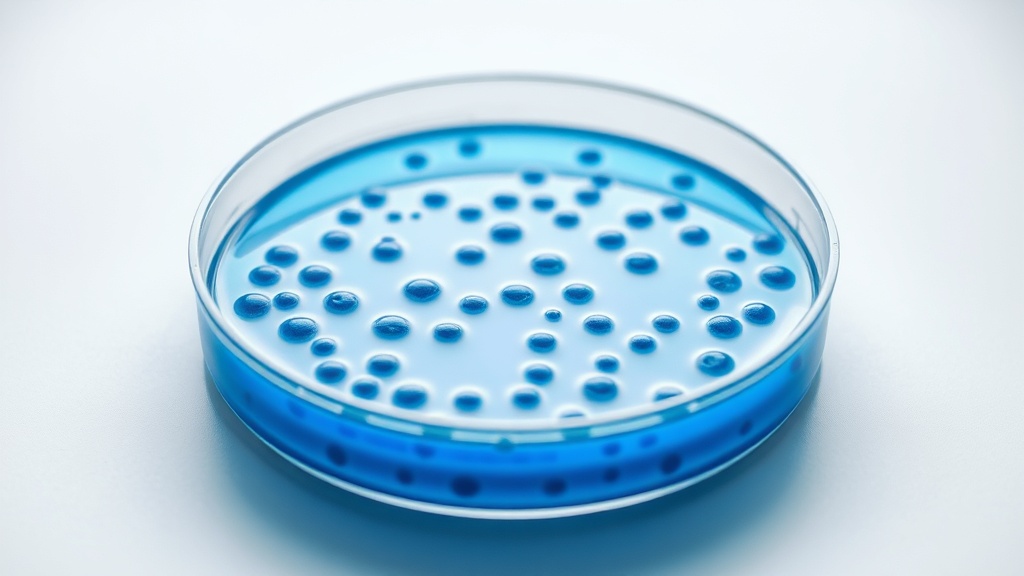
EPA Sued Over Crops Sprayed With Human Antibiotics

Home / Health / EPA Sued Over Crops Sprayed With Human Antibiotics
EPA Sued Over Crops Sprayed With Human Antibiotics
30 Nov, 2025
Summary
- Farms spray 8 million pounds of antibiotic and antifungal pesticides yearly.
- This practice may cause superbugs and sicken farm workers.
- Groups want EPA to stop allowing antibiotics on food crops.
A legal petition has been filed against the Environmental Protection Agency (EPA) by a coalition of public health and farm worker organizations. They are demanding the EPA cease its approval of spraying antibiotics and antifungals on U.S. food crops. This agricultural practice involves approximately 8 million pounds of these substances annually, many of which are banned in other countries.
The core of the concern is the link between this widespread pesticide use and the rise of antibiotic-resistant bacteria, commonly known as superbugs. The groups argue that this overuse of essential human medicines on crops directly contributes to increased risks of dangerous infections for the general population and poses health hazards to farm workers.
Alternatives like improved crop management and disease-resistant varieties are proposed by advocates, who emphasize that the long-term public health consequences of spraying human medicines on food outweigh agricultural benefits. The petition initiates a process that could take years, with legal action possible if the EPA does not act.




